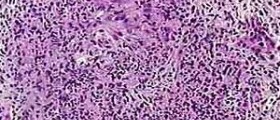

Can I please call on you for some help and information? I really need to know what the prognosis is for infant patients with adactylia unilateral, perhaps already diagnosed in utero. Can these patients survive and what treatment is necessary to make this possible? Thank you ever so much for any replies.
Loading...